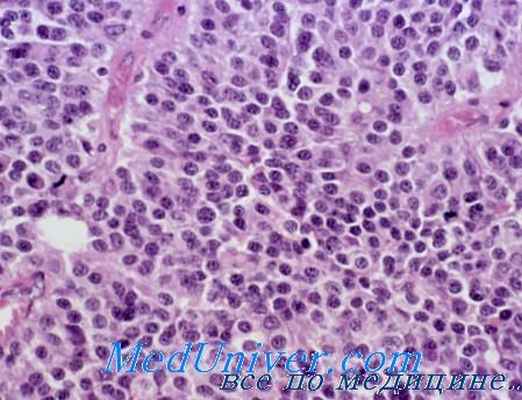
аденома гипофиза

Акромегалия - патологическая анатомия, морфология
Добавил пользователь Владимир З. Обновлено: 23.11.2025
Несмотря на очевидный прогресс в совершенствовании медицинской помощи, лечение акромегалии остается сложной задачей. Об эффективных алгоритмах лечения больных с акромегалией шла речь на секционном заседании, посвященном мультидисциплинарным подходам в терапии заболевания, проходившем в рамках VI Московской конференции эндокринологов.
- КЛЮЧЕВЫЕ СЛОВА: медицинский форум эндокринологов, фармакотерапия, акромегалия, эндокринология
Несмотря на очевидный прогресс в совершенствовании медицинской помощи, лечение акромегалии остается сложной задачей. Об эффективных алгоритмах лечения больных с акромегалией шла речь на секционном заседании, посвященном мультидисциплинарным подходам в терапии заболевания, проходившем в рамках VI Московской конференции эндокринологов.
Акромегалия – это тяжелое нейроэндокринное заболевание, обусловленное длительным воздействием на организм повышенной концентрации соматотропного гормона (СТГ). Клиническими проявлениями акромегалии являются диспропорциональный периостальный рост костей, увеличение размеров мягких тканей и внутренних органов, развитие сочетанных системных и обменных нарушений. По данным, представленным модератором заседания, главным эндокринологом Москвы М.Б. АНЦИФЕРОВЫМ (главный врач Эндокринологического диспансера, заслуженный врач РФ, д. м. н., профессор), в Москве на диспансерном учете состоит 296 больных акромегалией. 196 человек (77%) получают медикаментозную терапию, в большинстве своем – аналогами соматостатина (71%), 61 пациент (23%) – только хирургическое лечение и лучевую терапию. «Мы используем медикаментозное лечение в среднем в течение 4 лет. На фоне этого мы достигаем достаточно хорошего результата: клиническое улучшение наблюдается у 92% пациентов, стабилизация роста опухоли – у 93% больных. То есть те средства, которые мы расходуем на лечение данной категории больных, себя оправдывают», – подчеркнул Михаил Борисович Анциферов.
Целями лечения акромегалии являются уменьшение клинических проявлений заболевания, прекращение роста опухоли гипофиза и достижение нормальных уровней биохимических маркеров заболевания, от которых зависит отдаленный прогноз. Современное лечение больных акромегалией включает хирургическое вмешательство (в большинстве случаев транссфеноидальную аденомэктомию) и медикаментозную терапию (с использованием протонного пучка, гамма-излучения или гамма-ножа). По словам доктора медицинских наук Л.Я. РОЖИНСКОЙ (ФГУ «Эндокринологический научный центр» МЗиСР РФ), каждый метод в отдельности не позволяет достичь ремиссии заболевания у большинства больных, что требует сочетания нескольких видов терапии. Транссфеноидальная аденомэктомия остается методом выбора при лечении акромегалии. Успешная операция приводит к быстрому снижению уровня гормона роста и в ряде случаев – к излечению заболевания. «Экстренное хирургическое вмешательство необходимо при прогрессирующих нарушениях зрения. Однако у 40–60% больных из-за большого размера и инвазивного роста опухоли радикальное удаление соматотропиномы невозможно и необходима дополнительная терапия», – отметила Людмила Яковлевна Рожинская. Среди возможных методов дополнительной терапии могут обсуждаться повторное оперативное вмешательство, лучевая или медикаментозная терапия. Однако повторная операция сопряжена с высоким риском послеоперационных осложнений, результат лучевой терапии отсрочен во времени и осложняется развитием гипопитуитаризма.
«В настоящее время медикаментозная терапия акромегалии широко используется у тех больных, у которых хирургическое лечение не позволило достичь стойкой ремиссии. Кроме того, возможно применение консервативного лечения в качестве терапии первой линии у больных, которые отказываются от хирургического вмешательства или находятся в тяжелом состоянии, что делает проведение операции невозможным», – констатировала докладчик. По мнению Л.Я. Рожинской, аналоги соматостатина являются препаратами выбора для большинства пациентов благодаря высокой эффективности: их применение позволяет остановить рост опухоли у большинства больных и значительно снизить уровни соматотропного гормона и инсулиноподобного фактора роста-1. Агонисты дофамина, хотя и имеют такие преимущества, как пероральный путь введения и относительно низкая стоимость, используются значительно реже.
Согласно международному консенсусу, консервативное лечение акромегалии все еще остается второй линией терапии после хирургического вмешательства. Однако известно, что предоперационное лечение аналогами соматостатина может улучшать исход транссфеноидальной аденомэктомии, в частности, в случае макроаденом. Чувствительность пациентов к терапии аналогами соматостатина зависит от наличия в опухолевых клетках соматостатиновых рецепторов 2-го подтипа. В настоящее время исследуются новые аналоги соматостатина, имеющие сродство с другими подтипами соматостатиновых рецепторов. Кроме того, новым в лечении акромегалии является разработка химерных молекул, воздействующих как на соматостатиновые, так и на дофаминовые рецепторы.
В.С. ПРОНИН (зам. директора клиники эндокринологии, доцент кафедры эндокринологии Первого МГМУ им. И.М. Сеченова, заслуженный врач РФ, к. м. н.) в своем выступлении сделал акцент на основных слагаемых успешного лечения акромегалии. На сегодняшний день акромегалия остается одной из актуальных проблем практического здравоохранения. Это обусловлено запоздалой диагностикой заболевания, распространенностью макроаденом гипофиза с признаками интраселлярной и интракраниальной компрессии, разнообразием клинико-морфологических вариантов опухолевого развития, наличием выраженных и, как правило, необратимых системных и обменных нарушений. Эти обстоятельства обусловливают необходимость комбинированного лечения с использованием наиболее эффективных способов с целью скорейшего достижения клинико-биохимической ремиссии. «При выборе лечебной стратегии необходимо учитывать возрастно-половые особенности клинического течения, особенности рецепторной архитектоники опухолевых клеток, выраженность осложнений, перспективы хирургического вмешательства, изначальную чувствительность к первичной и вторичной медикаментозной терапии», – уточнил докладчик.
Среди фармакологических средств, активно используемых в лечении акромегалии, особое место, по мнению В.С. Пронина, занимают аналоги соматостатина, обладающие выраженным антисекреторным и антипролиферативным действием. К сожалению, в 30% случаев наблюдается первичная резистентность к действию аналогов соматостатина, ограничивающая сферу их применения. В этой связи непременным условием успешного лечения акромегалии является назначение комбинированной терапии с использованием преимуществ различных методов лечения.
Об эволюции в лечении акромегалии рассказал в своем выступлении А.Ю. ГРИГОРЬЕВ (зав. нейрохирургическим отделением ФГУ ЭНЦ МЗиСР РФ, к. м. н.). Хирургический метод, предложенный в 1893 г. нейрохирургом Франком Т. Полем (Frank Thomas Paul), стал первым методом лечения акромегалии: именно тогда нейрохирург провел первую операцию по удалению соматотропиномы у молодой женщины, страдающей акромегалией, транскраниальным височным доступом. Однако первое транссфеноидальное вмешательство по поводу акромегалии было осуществлено в 1908 г. нейрохирургом Юлиусом Хохенеггом (Julius Hochenegg). В течение последующих нескольких десятилетий транскраниальная хирургия прочно завоевала лидирующее положение в лечении аденом гипофиза, в частности соматотропином, благодаря влиянию Харви У. Кушинга (Harvey Williams Cushing). Но только в начале 70-х гг. ХХ века транссфеноидальный доступ окончательно утвердился в лечении акромегалии. Параллельно хирургическому методу активно развивался лучевой метод лечения заболевания.
Впервые его применил в 1909 г. Антуан Беклер (Antoine Béclère) при соматотропиноме. Однако, по словам докладчика, на сегодняшний день даже появление радиохирургических методов лучевой терапии не позволило ей удержать первенство в лечении акромегалии из-за большого количества осложнений и значительной отсрочки эффекта лечения. Медикаментозное лечение также прошло путь развития от эмпирического до патогенетического подхода. В начале прошлого века медикаментозная терапия включала в себя препараты йода, мышьяка, стрихнина, кофеина, ртути. Лечение эстрогенами вызывало положительную динамику клинических симптомов и состояния углеводного обмена без нормализации уровня СТГ. Затем был применен супрессивный эффект медроксипрогестерона и других препаратов, пока не была открыта способность подавления уровня СТГ у допаминового агониста – бромкриптина, благодаря чему стала активно развиваться и применяться эта группа препаратов.
«После открытия в 1972 г. гипоталамического фактора, регулирующего секрецию гормона роста, названного впоследствии соматостатином, началась эра его аналогов. На сегодняшний день неудобство применения короткодействующих форм привело к появлению пролонгированных аналогов соматостатина, которые отличает более удобная форма введения и удлиненный интервал времени введения при сопоставимой эффективности», – отметил А.Ю. Григорьев. Таким образом, сегодня алгоритм лечения заболевания представлен эндоскопической хирургией с интраоперационной навигацией и МРТ-контролем, применением длительно действующих аналогов соматостатина и лучевой хирургией. Все докладчики, выступавшие на секционном заседании, отметили, что важной составляющей медицинской помощи при акромегалии является разработка индивидуализированной лечебной стратегии с учетом клинико-морфологических особенностей опухолевого процесса, степени тяжести заболевания и чувствительности к лечебному воздействию.
Морфологическая характеристика, осложнения акромегалии.
сопровождающееся непропорциональным ростом костей скелета, мягких тканей, внутренних органов и рядом обменных нарушений. В основе акромегалии лежит избыточная продукция соматотропного гормона (гормона роста эозинофильными клетками передней доли гипофиза.. Появляются общая слабость, быстрая утомляемость, головные боли, парестезии и жгучие боли в руках, мышечная слабость. Постепенно увеличиваются конечности, нос, губы, подбородок (рис.). Нижняя челюсть выдвигается вперед по отношению к верхней. Увеличиваются промежутки между зубами. Язык не помещается во рту. Голос становится грубым и хриплым. Нарушается функция половых желез (нарушение менструального цикла у женщин, половое бессилие у мужчин), щитовидной железы (гипо- либо гиперфункция). Может развиться сахарный диабет. При сдавлении опухолью гипофиза перекреста зрительных нервов возникают расстройства зрения (сужение полей зрения, снижение остроты зрения). Прогноз при доброкачественном течении акромегалии в отношении жизни итрудоспособности благоприятный. Этиология неизвестна. Наиболее характерные проявления акромегалии развиваются под влиянием избыточно поступающего в организм гормона роста, что обусловлено гиперфункцией эозинофильных клеточных образований передней доли гипофиза в связи с аденомой или гиперплазией их. Ряд симптомов вызван вторичными нарушениями других эндокринных желез, функционально связанных с гипофизом, а также изменениями примыкающей к гипофизу диэнцефальной области.. Патологическая анатомия. Опухоль передней доли гипофиза, лежащая в основе акромегалии, является, как правило, доброкачественной аденомой из эозинофильных клеток, реже бывает злокачественной. Она может прорастать хиазму, головной мозг, клиновидную кость. Иногда опухоль развивается в клиновидной кости или по ходу кранио-фарингеального канала. В некоторых случаях наряду с аденомой гипофиза описаны аденомы околощитовидных, щитовидной, поджелудочной желез, коркового слоя надпочечников. При акромегалии наблюдаются спланхномегалия, склероз поджелудочной железы, гиперплазия щитовидной, зобной, околощитовидных желез. Иногда развивается гиперплазия лимфатических узлов. Изменения костно-суставной системы у больных с незакрытыми эпифизарными зонами роста выражаются в развитии пропорционального гигантизма.
Прогноз зависит от характера процесса в гипофизе. Причиной смерти могут быть интеркуррентные инфекции, сопротивляемость к которым у больных акромегалией понижена.
Морфологическая характеристика несахарного диабета.
Несахарный диабет - заболевание, связанное с понижением содержания в крови нейрогипофизарного гормона, - вазопрессина. Недостаток вазопрессина приводит к уменьшению реабсорбции воды в канальцах почек, выделению большого количества мочи с низким удельным весом. Вследствие большой потери жидкости мочой возникает жажда.
Несахарный диабет является нередким симптомом различных патологических процессов в диэнцефало-гипофизарной области. Как самостоятельная болезненная форма несахарный диабет рассматривается тогда, когда он не сопровождается другими видимыми нарушениями функции гипофиза или гипоталамуса. Повреждение нейрогипофиза или гипоталамуса может быть вызвано различными патологическими процессами. заболевание могло быть связано с инфекцией (сифилис, тиф, грипп, скарлатина, коклюш, пневмония, сепсис, малярия), с травмой, с опухолью; иногда у больных отсутствовала связь, несахарного диабета с какими-либо предшествовавшими заболеваниями. развития несахарного диабета у больных острым лейкозом, у которых при посмертном исследовании была обнаружена массивная инфильтрация задней доли гипофиза лейкемическими клетками. : диабет возник в связи с первичной или метастатической опухолью диэнцефало-гипофизарной области, несомненную роль играет генетический фактор, причем наследование болезни происходит по доминантному типу.
Патогенез и причины несахарного диабета
Стойкий несахарный диабет закономерно возникает при повреждении супраоптических ядер или гипоталамо-гипофизарного тракта выше срединного возвышения. Вопрос об этиологии и патогенезе «идиопатического» несахарного диабета остается во многом неясным. Описан так же тип несахарного диабета, связанный с повышенной инактивацией вазопрессина в печени и в почках вследствие нарушения ферментных. Выведение из организма большого количества воды и понижение осмотического давления плазмы вызывает раздражение «центра жажды», расположенного в гипоталамусе, что приводит к резкому повышению потребления воды. При неповрежденном «центре жажды» потеря воды мочой у больных несахарным диабетом полностью компенсируется приемом жидкости.
Акромегалия - патологическая анатомия, морфология
Акромегалия - патологическая анатомия, морфология
Одним из заболеваний гипофиза и диэнцефало-гипофизарной области головного мозга является акромегалия. Причиной развития данной патологии обычно является опухоль передней доли гипофиза. Чаще всего это эозинофильная аденома, имеющая доброкачественный характер. В исключительно редких случаях, как полагают Н. Gushing, McLean, М. Л. Бирюков, Е. Н. Логинов, эозинофильная аденома приобретает злокачественный характер.
Растет опухоль, как правило, медленно, размеры ее небольшие, но иногда эти новообразования бывают и более крупными, достигая 3—4 см в поперечнике, и нередко вызывают деструктивные изменения турецкого седла. Эти эозинофильные опухоли аденогипофиза обычно содержат большое количество соматотропного гормона — гормона роста (A. Segaloff и др., С. Gemzell, D. Jokkos, R. Luft, M. И. Балаболкин).
Снаружи эозинофильная аденома покрыта сравнительно плотной соединительнотканной капсулой и сама опухоль имеет эластическую консистенцию. На разрезе данное новообразование розоватого или сероватого оттенка, однородного строения.
При микроскопическом исследовании видно, что паренхима опухоли состоит преимущественно из дистрофически измененных эозинофильных клеток. Местами встречаются также главные и хромофобпые клетки гипофиза. Описаны случаи, когда типичная клиническая картина акромегалии наблюдается при ацидофильных, базофильных, хромофобных и смешанных ацидофильно-хромофобных доброкачественных опухолях аденогипофиза. При электронномикроскопическом изучении ацидофильной аденомы гипофиза определяются два типа ацидофильных клеток.
В клетках первого типа ядро имеет многочисленные впячивания и содержит одпо или два ядрышка. Митохондрии округлой или удлиненной формы содержат много крист. Гранулы умеренной электронной плотности, размером примерно 3300 А; располагаются они в одном из полюсов клетки. Аппарат Гольджи обычно развит очень слабо.
В клетках второго типа гранул меньше, но они окружены мембраной, причем между мембраной и центральным ядром гранулы имеется светлая зона. Аппарат Гольджи в этих клетках выражен более отчетливо. Как отмечают W. Gusek, R. R. Cardell, R. S. Knighton, Т. Fukumitsu, эндоплазматический ретикулум как в первом, так и во втором типе клеток имеет везикулярное строение, причем встречаются фигуры из изогнутых мембран.
В хромофобной же аденоме гипофиза выявляются клетки, содержащие небольшое количество гранул с относительно низкой электронной плотностью. Размеры этих гранул колеблются от 50 до 350 А. Эндоплазматический ретикулум представлен отдельными мембранами, среди которых свободно располагаются рибосомы. Митохондрии, как отмечает U. Schelin, бывают чаще удлиненной формы с продольными кристами, ядро имеет глубокие впячивапия. Ограничительная клеточная мембрана волнистая и образует многочисленные отростки.
Среди полиморфных клеток опухоли нередко обнаруживаются лейкоцитарные воспалительные инфильтраты, в них отмечается значительное количество полинуклеаров. Синусообразные тонкостенные капилляры и мелкие сосуды переполнены кровью. В слаборазвитой соединительнотканной основе часто встречаются небольшие диффузные очаги кровоизлияний. Иногда наблюдаются массивные спонтанные кровоизлияния в паренхиму адепомы гипофиза, которые образуют полости, заполненные кровью.
Медленно растущая аденома, достигнув определенных размеров, оказывает давление на зрительный нерв и может вызывать его атрофию. Иногда опухоль сдавливает и другие черепномозговые нервы, что приводит к появлению соответствующих неврологических симптомов. В случаях, когда различные аденомы гипофиза, вызывающие акромегалию, приобретают злокачественный характер роста, их клеточные элементы становятся полиморфными, усиливаются пролиферативные процессы, увеличивается количество митозов.
Среди быстрорастущих клеток часто встречаются очаги некроза, множественные диффузные кровоизлияния, пролиферация железистых структур. Известны случаи акромегалии при ангиоме или менингеоме (при отсутствии опухолевых изменений в паренхиматозных клетках самого аденогипофиза).
Кардиореспираторные нарушения при акромегалии
Для цитирования: Ковалева Ю.А., Иловайская И.А., Древаль А.В., Старостина Е.Г. Кардиореспираторные нарушения при акромегалии. РМЖ. Медицинское обозрение. 2016;24(1):19-24.
Статья посвящена патологии сердечно-сосудистой системы при акромегалии, особое внимание уделено кардиореспираторным нарушентям при акромегалии
Для цитирования. Ковалева Ю.А., Иловайская И.А., Древаль А.В., Старостина Е.Г. Кардиореспираторные нарушения при акромегалии // РМЖ. 2016. No 1. С. 19–24.
1. Ben-Sholmo A., Melmed S. Acromegaly // Endocrinol Metab Clin North Am. 2008. 37. P.101–122.
2. Древаль А.В. Эндокринология: руководство для врачей. М.: ГЭОТАР-Медиа, 2016. 554 с.
3. Hoskuldsdottir G.T., Fjalldal S.B., Sigurjonsdottir H.A. The incidence and prevalence of acromegaly, a nationwide study from 1955 through 2013 // Pituitary. 2015. Vol. 18 (6). Р. 803–807.
4. Dekkers O.M., Biermasz N.R., Pereira A.M. et al. Mortality in Acromegaly: A Metaanalysis // J Clin Endocrinol Metab. 2008. Vol. 93(1). Р. 61–67.
5. Mestron A., Webb S.M., Astorga R., et al. Epidemiology, clinical characteristics, outcome, morbidity and mortality in acromegaly based on the Spanish Acromegaly Registry (Registro Espanol de Acromegalia, REA) // Eur J Endocrinol. 2004. Vol. 151. P. 439–446.
6. Colao A., Ferone D., Marzullo P. et al. Systemic complications of acromegaly: epidemiology, pathogenesis, and management. Endocrine Reviews // 2004. Vol. 25. P.102–152.
7. Holdaway I.M., Bolland M.J., Gamble G.D. A meta-analysis of the effect of lowering serum levels of GH and IGF-1 on mortality in acromegaly // European Journal of Endocrinology. 2008. Vol. 159. P. 89–95.
8. Melmed S. Acromegaly and cancer: not a problem // Journal of Clinical Endocrinology and Metabolism. 2001. Vol. 86. P. 2929–2934.
9. Clayton RN. Cardiovascular function in acromegaly // Endocr Rev. 2003. Vol. 24. P. 272–277.
10. Древаль А.В., Покрамович Ю.Г., Нечаева О.А., Камынина Т.С. Московский областной регистр больных акромегалией // Проблемы эндокринологии. 2008. Т. 54. № 4. С. 27–31.
11. Ciulla M., Arosio M., Barelli M.V. et al. Blood-pressure independent cardiac hypertrophy in acromegalic patients // J Hypertens. 1999. Vol..17. P.1965–1969.
12. Colao P. Marzullo C., Di Somma et al. Growth hormone and the heart // Clinical Endocrinology. 2001. Vol. 54. P. 137–154.
13. Frustaci A. Test, Cell death in acromegalic cardiomyopathy // Circulation. 1999. Vol. 99. P.1426–1434.
14. Ito H., Hirata Y., Adachi S. et al. Endothelin-1 is an autocrine/paracrine factor in the mechanism of angiotensin II-induced hypertrophy in cultured rat cardiomyocytes // J Clin Invest. 1993. Vol. 92. P. 398–403.
15. Ito H., Hiroe M., Hirata Y. et al. Insulin-like growth factor-I induces hypertrophy with enhanced expression of muscle specific genes in cultured rat cardiomyocytes // Circulation. 1993. Vol. 87. P.1715–1721.
16. Donath M., Zapf J., Eppenberger-Eberhardt M. et al., Insulin-like growth factor I stimulates myofibril development and decreases smooth muscle alpha-actin of adult cardiomyocytes // Proc. Natl. Acad. Sci. USA. 1994. Vol. 91. P. 1686–1690.
17. Fuller S.J., Mynett J.R., Sugden P.H. Stimulation of cardiac protein synthesis by insulin-like growth factors // Biochem. J. 1992. Vol. 282(1). P. 85–90.
18. Schnabel P., Mies F., Nohr T. et al. Differential regulation of phospholipase C-beta isozymes in cardiomyocyte hypertrophy // Biochem. Biophys. Res. Commun. 2000. Vol. 275. P. 1–6.
19. Lu C., Schwartzbauer G., Sperling M.A. et al. Demonstration of direct effects of growth hormone on neonatal cardiomyocytes // J. Biol. Chem. 2001. Vol. 276. P. 22892–22900.
20. Пронин В.С., Молитвословова Н.Н. Акромегалия. Этиология, патогенез, клиника, диагностика, лечение / под ред. акад. РАН и РАМН И.И. Дедова, чл.-корр. Г.А. Мельниченко. М., 2009. 256 с.
21. Li Q., Li B., Wang X. et al. Overexpression of insulin-like growth factor-1 in mice protects from myocyte death after infarction, attenuating ventricular dilation, wall stress, and cardiac hypertrophy // J. Clin. Invest. 1997. Vol. 100. P. 1991–1999.
22. Buerke M., Murohara T., Skurk C. et al. Cardioprotective effect of insulin-like growth factor I in myocardial ischemia followed by reperfusion // Proc. Natl. Acad. Sci. USA. 1995. Vol. 92. P.8031–8035.
23. Butt R.P., Laurent G.J., Bishop J.E. Collagen production and replication by cardiac fibroblasts is enhanced in response to diverse classes of growth factors // Eur. J. Cell Biol. 1995. Vol. 68. P.330–335.
24. Fazio S., Cittadini A., Biondi B. et al. Cardiovascular effects of short-term growth hormone hypersecretion // J Clin Endocrinol Metab. 2000. Vol. 85. P.179–182.
25. Lopez-Velasco R., Escobar-Morreale H.F., Vega B. et al. Cardiac involvement in acromegaly: specific myocardiopathy or consequence of systemic hypertension? // J Clin Endocrinol Metab. 1997. Vol. 82. P. 1047–1053.
26. Stro¨mer H., Cittadini A., Douglas P. et al. Exogenously administered growth hormone and insulin-like growth factor-I alter intracellular Ca2? handling and enhance cardiac performance. In vitro evaluation in the isolated isovolumic buffer-perfused rat heart // Circ. Res. 1996. Vol. 79. P.227–236.
27. Tajima M., Weinberg E., Bartunek J. et. al. Treatment with growth hormone enhances contractile reserve and intracellular calcium transients in myocytes from rats with postinfarction heart failure // Circulation. 1999. Vol. 99. P. 127–134.
28. Stro¨mer H., Cittadini A., Grossman J.D. et. al., Intrinsic cardiac muscle function, calcium handling and beta -adrenergic responsiveness is impaired in rats with growth hormone deficiency // Growth Horm IGF Res. 1999. Vol. 9. P. 262–271.
29. Ren J., Brown-Borg H. Impaired cardiac excitation-contraction coupling in ventricular myocytes from Ames dwarf mice with IGF-I deficiency // Growth Horm. IGF Res. 2002. Vol. 12. P. 99–105.
30. Isgaard J., Arcopinto M., Karason K. et. al. GH and the cardiovascular system: an update on a topic at heart // Endocrine. 2015. Vol. 48. P. 25–35.
31. Colao A., Pivonello R., Grasso L. et al. Determinants of cardiac disease in newly diagnosed patients with acromegaly. Results of a 10 year survey study // Eur J Endocrinol. 2011. Vol. 165. P.713–721.
32. Smallridge R.C., Rajfer S., Davia J. et al. Acromegaly and the heart, an echocardiographic study // Am J Med. 1979. Vol. 66. P. 22–27.
33. Vitale G., Pivonello R., Lombardi G. et al. Cardiac abnormalities in acromegaly: pathophysiology and implications for management // Treatments in Endocrinology. 2004. Vol. 3 (5). P. 309–318.
34. Melmed S., Casanueva F., Klibanski A. et al. A consensus on the diagnosis and treatment of acromegaly complications // Pituitary. 2013. Vol. 16. P. 294–302.
35. Giustina A., Casanueva F., Cavagnini F. et al. Diagnosis and treatment of acromegaly complications // J Endocrinol Invest. 2003. Vol. 26. P.1242–1247.
36. Kehaly G., Olshausen K.V., Mohr-Kahaly S. et al. Arrhythmia profile in acromegaly // European Heart Journal. 1992. Vol. 13 (1). P. 51–56.
37. Herrmann B., Bruch C., Saller B. Occurrence of ventricular late potentials in patients with active acromegaly // Clin. Endocrinol. 2001. Vol. 55. P. 201–207.
38. Colao A., Spinelli L., Marzullo P. et al. High prevalence of cardiac valve disease in acromegaly: an observational, analytical, case-control study. Journal of Clinical Endocrinology and Metabolism // 2003. Vol. 88 (7). P. 3196–3201.
39. Lindroos M., Kupari M., Heikkila J. et al. Predictors of left ventricular mass in old age: an echocardiographic, clinical and biochemical investigation of a random population sample // Eur Heart J. 1994. Vol. 15. P. 769–780.
40. Palmieri V., Wachtell K., Gerdts E. et al. Left ventricular function and hemodynamic features of inappropriate left ventricular hypertrophy in patients with systemic hypertension: the LIFE study // Hypertension. 2001. Vol. 141. P. 784–791.
41. Berg C., Petersenn S., Lahner H. et al. Cardiovascular Risk Factors in Patients with Uncontrolled and Long-Term Acromegaly: Comparison with Matched Data from the General Population and the Effect of Disease Control // J Clin Endocrinol Metab. 2010. 95 (8). P. 3648–3656.
42. Lombardi G., Galdiero M., Auriemma R., et al. Acromegaly and the cardiovascular system // Neuroendocrinology. 2006. Vol. 83. P. 211–217.
43. Dreval A., Trigolosova I., Misnikova I. et al. Prevalence of diabetes mellitus in patients with acromegaly // Endocrine Connections. 2014. Vol. 3. P. 93–98.
44. Greenland P., Gaziano J.M. Clinical practice. Selecting asymptomatic patients for coronary computed tomographic exercise testing // N Engl J Med 2003. Vol. 349. P. 465–473.
45. Cannavo S., Almoto B., Cavalli G. et al. Acromegaly and coronary disease: an integrated evaluation of conventional coronary risk factors and coronary calcifications detected by computed tomography // Journal of Clinical Endocrinology and Metabolism. 2006. Vol. 91 (10). P. 3766–3772.
46. Colao A., Spiezia S., Cerbone G. et al. Increased arterial intima-media thickness by B-M mode echodoppler ultrasonography in acromegaly // Clinical Endocrinology. 2001. Vol. 54 (4). P.515–524.
47. Lie J.T., Grossman S.J. Pathology of the heart in acromegaly: anatomic findings in 27 autopsied patients // American Heart Journal. 1980. Vol. 100. P. 41–52.
48. Otsuki M., Kasayama S., Hiroyasu Y. et al. Characterization of premature atherosclerosis of carotid arteries in acromegalic patients // Clinical Endocrinology. 2001. Vol. 54. P. 791–796.
49. Hiroyoshi A., Kreutzer J., Wasmeier G. Acromegaly per se does not increase the risk for coronary artery disease // European Journal of Endocrinology. 2010. Vol. 162. P. 879–886.
50. Delafontaine P., Lou H., Alexander R.W. Regulation of insulin-like growth factor 1 messenger RNA levels in vascular smooth muscle cells // Hypertension. 1991. Vol. 18. P. 742–747.
51. Herrmann B., Severing M., Schmermund A. et al. Impact of disease duration on coronary calcification in patients with acromegaly // Exp Clin Endocrinol Diabetes. 2009. Vol. 117. P. 417–422.
52. McNicholas W.T, Bonsignore M.R. Sleep apnoea as an independent risk factor for cardiovascular disease: Current evidence, basic mechanisms and research priorities // Eur Respir J. 2007. Vol.29. P.156–178.
53. Peppard P., Young T., Palta M. et al. Prospective study of the association between sleep-disordered breathing and hypertension // N Engl J Med. 2000. Vol. 342. P. 1378–1384.
54. Parati G., Lombardi C., Hedner J. et al. Recommendations for the management of patients with obstructive sleep apnoea and hypertension // Eur Respir J. 2013. Vol. 41. P. 523–538.
55. Monahan K., Storfer-Isser A., Mehra R. et al. Triggering of nocturnal arrhythmias by sleep-disordered breathing events // J Am Coll Cardiol. 2009. Vol. 54. P. 1797–1804.
56. Peker Y., Kraiczi H., Hedner J. et al. An independent association between obstructive sleep apnoea and coronary artery disease // Eur Respir J. 1999. Vol. 14. P. 179–184.
57. Young T., Finn L., Peppard P. et al. Sleep disordered breathing and mortality: eighteen-year follow-up of the Wisconsin sleep cohort // Sleep. 2008. Vol. 31. P.1071–1078.
58. Fatti L., Scacchi M., Pincelli A. et al. Prevalence and pathogenesis of sleep apnea and lung disease in acromegaly // Pituitary. 2001. Vol. 4. P. 259–62.
59. Bouscoulet L., Vazquez-Garcia J., Muino A. et al. Prevalence of sleep related symptoms in four Latin American cities // J Clin Sleep Med. 2008. Vol. 4. P. 579–85.
60. Grunstein R., Ho K., Sullivan C. Sleep apnea in acromegaly // Annals of Internal Medicine. 1991. Vol. 115. P. 527–532.
61. Weiss V., Sonka K., Pretl M. et al. Prevalence of the sleep apnea syndrome in acromegaly population // Journal of Endocrinological Investigation. 2000. Vol. 23. P. 515–519.
62. Perks W., Horrocks P., Cooper R. et al. Sleep apnoea in acromegaly // BMJ. 1980. Vol. 280. P.894–897.
63. Hart T.B., Radow S.K., Blackard W.G. et al. Sleep apnoea in active acromegaly // Archives of Internal Medicine. 1985. Vol. 145. P. 865–866.
64. Maison P., Tropeano A., Macquin-Mavier I. et al. Impact of somatostatin analogs on the heart in acromegaly: a metaanalysis // J Clin Endocrinol Metab. 2007. Vol. 92. P. 1743–1747.
65. Colao A. Improvement of cardiac parameters in patients with acromegaly treated with medical therapies // Pituitary. 2012. Vol. 15. P. 50–58.
66. Maione L., Garcia C., Bouchachi A. et al. No evidence of a detrimental effect of cabergoline therapy on cardiac valves in patients with acromegaly // J Clin Endocrinol Metab. 2012. Vol. 97. P.2012–1833.
67. Sze L., Schmid C., Bloch K. et al. Effect of ranssphenoidal surgery on sleep apnoea in acromegaly // European Journal of Endocrinology. 2007. Vol. 156. P. 321–329.
68. Piper J.G., Dirks B.A., Traynelis V.C. et al. Perioperative management and surgical outcome of the acromegalic patient with sleep apnea // Neurosurgery. 1995. Vol. 36. P. 70–75.
69. Pekkarinen T., Partinen M., Pelkonen R. et al. Sleep apnoea and daytime sleepiness in acromegaly: relationship to endocrinological factors // Clinical Endocrinology. 1987. Vol. 27. P.649–654.
70. Saeki N., Isono S., Nishino T. et al. Sleep-disordered breathing in acromegalics-relation of hormonal levels and quantative sleep study by means of bedside oximeter // Endocrine Journal. 1999. Vol. 46. P. 585–590.
71. Tolis G., Angelopoulos N., Katounda E. et al. Medical treatment of acromegaly: comorbidities and their reversibility by somatostatin analogs // Neuroendocrinology. 2006. Vol. 83. P.249–257.
72. Grunstein R.R., Ho K.K., Sullivan C.E. Effect of octreotide, a somatostatin analog, on sleep apnea in patients with acromegaly // Annals of Internal Medicine. 1994. Vol. 121. P. 478–483.
Контент доступен под лицензией Creative Commons «Attribution» («Атрибуция») 4.0 Всемирная.
Патогенетическая связь метаболических нарушений и гинекологической патологии при акромегалии: представление клинического случая
Акромегалия – нейроэндокринное заболевание, характеризующееся развитием множественных коморбидных состояний. В представленном клиническом наблюдении у пациентки наблюдалось длительное течение акромегалии, без ремиссии после трансназальной транссфеноидальной аденомэктомии и длительного лечения аналогами соматостатина пролонгированного действия. Восстановление циклической овариальной функции после первого нейрохирургического вмешательства на фоне прогрессирования метаболических нарушений вследствие акромегалии привели к клинической манифестации аденомиоза, что проявилось альгоменореей и менометроррагией с развитием железодефицитной анемии средней степени тяжести. «Клинически активный» аденомиоз явился показанием к выполнению экстирпации матки с маточными трубами. Данный случай подчеркивает необходимость проведения своевременного диагностического поиска у пациенток позднего репродуктивного и пременопаузального возраста, страдающих акромегалией, на предмет доброкачественной патологии матки и своевременного установления показаний к оперативному лечению выявленных гинекологических нарушений.
Ключевые слова
Для цитирования:
For citation:
Актуальность
Акромегалия – нейроэндокринное заболевание, обусловленное гиперпродукцией соматотропного гормона (СТГ) опухолью гипофиза, приводящей к повышению концентрации инсулиноподобного фактора роста 1 (ИРФ-1) [1]. Система СТГ/ИРФ-1, как один из ключевых факторов регуляции многих метаболических и энергетических процессов в организме, определяет широкий спектр клинических проявлений при СТГ-продуцирующих аденомах гипофиза [2].
По данным зарубежных исследователей, распространенность акромегалии составляет около 60–85 случаев на 1 млн населения [3, 4]. Клинические проявления при акромегалии связаны как с избытком СТГ и ИРФ-1 (изменение черт лица, увеличение размеров кистей и стоп, потливость, синдром ночного апноэ, артропатии, артериальная гипертензия, кардиопатия и нарушения углеводного обмена), так и масс-эффектом опухоли (головные боли, нарушения зрения, гипопитуитаризм) [5]. Значительный интерес представляет повышение риска эпителиальных опухолей различной локализации, а также скомпрометированность механизмов регуляции и поддержания циклического ремоделирования органов женской репродуктивной системы [6, 18].
Период от появления первых симптомов заболевания до подтверждения диагноза обычно составляет 7–10 лет [7], в связи с чем различные системы органов долгое время функционируют в условиях усиленного ИРФ-1-сигналинга. Отсутствие лечения, направленного на снижение СТГ и ИРФ-1, приводит к ухудшению качества жизни, прогрессированию коморбидных состояний и повышению смертности [8–10]. Своевременное лечение основного заболевания и коррекция осложнений (табл. 1) способствуют увеличению продолжительности жизни [7].
Таблица 1. Коморбидные состояния при акромегалии
Нарушения обмена глюкозы
Гипертрофия миокарда, кардиомиопатия, застойная сердечная недостаточность, ишемическая болезнь сердца, аритмии, артериальная гипертензия
Синдром ночного апноэ, макроглоссия, обструкция верхних дыхательных путей
Утолщение суставных поверхностей, артропатии, синдром запястного канала, компрессионные переломы позвонков
Образования желудочно-кишечного тракта, щитовидной железы
Нарушения менструального цикла, гиперкальциурия
Первый этап диагностики включает в себя оценку клинических проявлений, определение ИРФ-1 и оценку снижения уровня СТГ после нагрузки глюкозой в ходе перорального глюкозотолерантного теста. При активной стадии заболевания уровень СТГ не снижается менее 1,0 нг/мл. При лабораторном подтверждении необходимо проведение МРТ головного мозга как наиболее информативного метода визуализации аденом гипофиза [3].
Методом выбора лечения акромегалии является хирургический – трансназальная транссфеноидальная аденомэктомия. При неэффективности оперативного вмешательства, что наблюдается приблизительно в 40–60% наблюдений, преимущественно при макроаденомах [4], возможно назначение медикаментозной терапии: аналогов соматостатина, агонистов дофамина и блокаторов рецепторов соматотропного гормона [11] В качестве третьей линии лечения используется радиохирургия [12]
Различные эндокринопатии рассматриваются рядом авторов в качестве важнейшего фактора риска развития и прогрессирования гиперпластических заболеваний и опухолей женской репродуктивной системы: эндометриоза, лейомиомы матки, гиперплазии эндометрия [13] В данной публикации представлено клиническое наблюдение пациентки с длительным течением акромегалии, резистентной к консервативному лечению, и развитием спектра коморбидных состояний, обменных нарушений и доброкачественной гинекологической патологии, а именно – аденомиоза.
Описание случая
Пациентка А., 40 лет.
Считает себя больной с 2007 г. (с 30-летнего возраста), когда отметила появление частых головных болей, плохо поддающихся купированию анальгетиками, прекращение менструаций. За медицинской помощью не обращалась, так как, со слов больной, отсутствие менструаций не требовало использования средств контрацепции при половой жизни. В анамнезе пациентка указывала четыре беременности, из них: первые три беременности закончились искусственным абортом на сроке до 12 нед по желанию женщины и четвертая (2000 г.) – самопроизвольными своевременными родами в головном предлежании без осложнений. В течение первых пяти лет после родов в качестве метода контрацепции использовался внутриматочный медьсодержащий контрацептив; далее от беременности не предохранялась.
С 2009 г. А. стала обращать внимание на изменения внешности: укрупнение черт лица, увеличение размера обуви, расширение межзубных промежутков, выраженную потливость. При обследовании в 2011 г. терапевтом по месту жительства диагностирована акромегалия: СТГ 43,7 нг/мл, ИРФ-1 836 нг/мл (115–307 нг/мл), при МРТ головного мозга выявлено инфра-, пара-, супраселлярное образование гипофиза, размерами 14х13 мм. Для определения дальнейшей лечебной тактики направлена в ФГБУ Эндокринологический научный центр МЗ РФ.
В 2012 г. в отделении нейроэндокринологии и остеопатий Эндокринологического научного центра МЗ РФ подтверждена активная стадия акромегалии, обусловленная наличием СТГ-продуцирующей макроаденомы гипофиза. Рекомендована и проведена трансназальная транссфеноидальная аденомэктомия: интраоперационно отмечалась инфильтрация твердой мозговой оболочки и ткани гипофиза опухолью. В послеоперационном периоде ремиссия заболевания не достигнута, пациентке рекомендована терапия аналогами соматостатина пролонгированного действия 20 мг 1 раз в 28 дней.
В 2013 г. начато лечение октреотидом в вышеуказанной дозировке. В связи с отсутствием нормализации ИРФ-1 на фоне лечения добавлен Бромокриптин в дозе 2,5 мг 2 раза в сутки. По данным МРТ не получено однозначных данных в пользу наличия остаточной опухолевой ткани.
В 2015 г. госпитализирована повторно. Несмотря на двухкомпонентную лекарственную терапию, сохранялась активная стадия заболевания (ИРФ-1 897,8 нг/мл) без визуализации остаточной ткани опухоли по данным МРТ, в связи с чем доза октреотида увеличена до 30 мг 1 раз в 28 дней. Пациентке рекомендовано продолжение консервативной терапии и динамическое наблюдение.
В отсутствие ремиссии после хирургического лечения и двухкомпонентной консервативной терапии, история развития заболевания закономерно включала спектр коморбидных состояний, обусловленных активной стадией акромегалии. Так, в 2011 г. выявлено выраженное нарушение углеводного обмена с клинической картиной острой метаболической декомпенсации: гликемия в дебюте составила 17,9 ммоль/л, что расценено как сахарный диабет вследствие акромегалии. Инициирована базис-болюсная инсулинотерапия гларгином и аспартом. В 2012 г. сохранялась декомпенсация углеводного обмена (HbA1c 8,6%), в ФГБУ ЭНЦ проведено обучение основам самоконтроля. С 2013 по 2015 гг. сохранялась компенсация углеводного обмена, HbA1c в динамике составлял не более 5,8%.
В 2012 г. перед нейрохирургическим вмешательством при проведении ультразвукового исследования щитовидной железы выявлен многоузловой зоб (два узловых образования в правой доле, диаметром 1,7 и 1,1 см, общий объем щитовидной железы – 30 мл), выполнена тонкоигольная аспирационная биопсия, по данным которой установлен диагноз узлового коллоидного зоба (Bethesda II). Далее ежегодно проводилось динамическое эхографическое исследование щитовидной железы – размеры узлов оставались без значимой динамики. Показатели тиреоидной функции – в пределах референсных значений.
В 2012 г., при обследовании перед нейрохирургическим вмешательством, установлена причина длительной аменореи (с 2007 года) – гипогонадотропный гипогонадизм. По данным лабораторного исследования: ЛГ 0,8 ед/л, ФСГ 2,7 ед/л, пролактин 227,8 мЕд/л, эстрадиол 64,3 пмоль/л. Отражением глубокой гипофункции яичников явилось значение толщины срединного маточного Эхо при трансвагинальной эхографии органов малого таза – 3 мм. После оперативного лечения в 2012 г. пациентка отметила восстановление менструального ритма: менструации стали длиться по 4–5 дней, через 23 дня и носили умеренный, безболезненный характер.
С 2016 г. А. стала отмечать увеличение менструальной кровопотери и резкую болезненность менструаций, требующую приема анальгетиков. В процессе диспансерного наблюдения по поводу основного заболевания отмечалось снижение гемоглобина до 70–100 г/л, цитологические признаки микроцитоза и анизоцитоза в клиническом анализе крови. По месту жительства проводилась симптоматическая терапия: назначены пероральные препараты железа с временным улучшением показателей «красной крови». Диагностический поиск на предмет источника хронической кровопотери не проводился, несмотря на регулярные осмотры гинекологом и проведение эхографии органов малого таза, которая выявляла диффузные изменения миометрия, соответствующие ультразвуковой картине аденомиоза.
Эхографические критерии диагноза эндометриоза матки в совокупности с характерными симптомами: альгоменореей и меноррагией, развитием хронической железодефицитной анемии, соответствовали диагнозу «активного» аденомиоза [13] – прогрессированию латентного доброкачественного гиперпластического заболевания матки на фоне длительного повышения ИРФ-1 и СТГ, сахарного диабета вследствие акромегалии и восстановления циклической функции яичников после нейрохирургического вмешательства в 2012 г.
Результаты физикального, лабораторного и инструментального исследования
В 2017 г. пациентка А. в плановом порядке поступила в ФГБУ Эндокринологический научный центр МЗ РФ для коррекции лечебной тактики, так как на фоне проводимой медикаментозной терапии октреотидом пролонгированного действия 30 мг 1 раз в 28 дней сохранялась активная стадия заболевания (ИРФ-1 690,4 нг/мл). На момент госпитализации длительность лечения аналогами соматостатина пролонгированного действия составила 4 года. При проведении МРТ визуализирована остаточная опухолевая ткань размером 10х11х7,5 мм, с пара- и эндоселлярным ростом.
В ходе госпитализации выявлена декомпенсация углеводного обмена (HbA1c – 7,6%). Пациентке повторно разъяснены принципы самоконтроля, скорректированы дозы аспарта и гларгина. На этом фоне показатели гликемического профиля достигли целевых значений. В ходе обследования данных за наличие микро- и макрососудистых осложнений сахарного диабета не получено. Ультразвуковое исследование щитовидной железы не выявило значимых изменений в размерах узловых образований, показатели тиреоидной функции в пределах референсных значений.
С 2015 г. отмечает длительные запоры. По данным УЗИ брюшной полости диагностированы множественные мелкие конкременты желчного пузыря. Эндоскопическое исследование толстой кишки позволило выявить множественные формирующиеся полипы прямой кишки. На фоне терапии слабительными препаратами стул нормализовался. Рекомендовано наблюдение у гастроэнтеролога, оперативное лечение по поводу калькулезного холецистита в плановом порядке.
Учитывая наличие остаточной ткани аденомы и отсутствие ремиссии на фоне медикаментозной терапии, решено выполнить повторное нейрохирургическое вмешательство.
В процессе предоперационного обследования выявлена железодефицитная анемия средней степени тяжести (гемоглобин 82 г/л, MCV 77 фл, MCH 21 пг, сывороточное железо 4,1 мкмоль/л, НТЖ 3,99%), инициирована терапия парентеральными препаратами железа. Принимая во внимание жалобы на болезненные и обильные менструации, проведено комплексное гинекологическое обследование: диагностирован диффузный «клинически активный» аденомиоз, альгоменорея, меноррагия; рекомендована экстирпация матки с маточными трубами в срочном порядке в качестве необходимого метода подготовки к нейрохирургическому вмешательству.
Лечение
Гистерэктомия произведена в условиях гинекологического отделения ФГБУ ЭНЦ МЗ РФ на фоне периоперационного внутривенного восполнения дефицита железа суммарной дозой 1000 мг. Послеоперационный период протекал без особенностей. Морфологическая картина удаленной матки соответствовала аденомиозу 2-й стадии распространения (поражение на глубину 2/3 миометрия). Преобладающим вариантом эндометриодных гетеротопий явились очаги с выраженным стромальным компонентом и ангиогенезом («морфологически активные» [13]). В окружающем миометрии наблюдалась лимфогистиоцитарная инфильтрация с чередованием участков фиброза. Маточные трубы характеризовались признаками хронического сальпингита и склерозом мышечной оболочки.
Результатом лечения в гинекологическом стационаре явилась нормализация показателей гемоглобина, эритроцитов и сывороточного железа, что явилось основанием для перевода в нейрохирургический стационар ФГБУ ЭНЦ МЗ РФ, на базе которого проведена повторная трансназальная транссфеноидальная аденомэктомия. Интраоперационно обнаружено, что опухоль располагалась в полости турецкого седла, прорастала твердую мозговую оболочку в области его дна, инфильтрировала медиальную стенку левого кавернозного синуса. Общее количество удаленной опухоли составило около 1 мл. В ходе попытки ревизии полости кавернозного синуса отмечено венозное кровотечение, что не позволило полноценно визуализировать полость седла. На пяты5-е сутки послеоперационного периода показатели СТГ составили: 4,41–3,75–4,04–4,27–4,28 нг/мл, таким образом, ремиссия заболевания не достигнута. Также в послеоперационном периоде развился вторичный гипотиреоз, что послужило основанием для назначения заместительной терапии левотироксином натрия. При выписке пациентке рекомендовано продолжение терапии аналогами соматостатина пролонгированного действия в дозе 30 мг 1 раз в 28 дней и контроль уровня ИРФ-1 через 3 мес.
Исход и результаты последующего наблюдения
На основании контрольных значений ИРФ-1 через 3 мес отмечено отсутствие ремиссии акромегалии, в связи с чем в качестве 3-й линии терапии рекомендовано проведение радиохирургического лечения.
В связи с безуспешностью попыток лекарственного и оперативного достижения ремиссии акромегалии у пациентки А., 40 лет, отмечено закономерное развитие спектра метаболических, костно-суставных и гинекологических нарушений. История развития гинекологической патологии включала первично функциональную патологию, связанную с нарушениями в иерархической оси регуляции циклической функции яичников: результирующими гипоэстрогенией и аменореей. Последующее восстановление сывороточного уровня эстрадиола потенцировало прогрессирование аденомиоза у пациентки с инсулинорезистентностью и сахарным диабетом вследствие акромегалии на фоне предшествовавших многократных внутриматочных вмешательств – трех искусственных абортов и морфологически подтвержденного хронического воспалительного процесса внутренних гениталий.
Заключение
Данное клиническое наблюдение подчеркивает важность дифференциальной диагностики функциональных и органических причин аномальных маточных кровотечений у пациенток позднего репродуктивного и пременопаузального возраста, страдающих акромегалией, а также своевременного установления показаний к оперативному лечению доброкачественных гиперпластических процессов у данного контингента больных, особенно на фоне отсутствия достижения ремиссии основного заболевания – важного фактора прогрессирования аденомиоза.
Дополнительная информация
Источник финансирования
Публикация настоящей работы поддержана грантом Президента Российской Федерации МД-3061.2017.7
Согласие пациента
Пациент добровольно подписал информированное согласие на публикацию персональной медицинской информации в обезличенной форме в журнале «Ожирение и метаболизм».
Конфликт интересов
Авторы декларируют отсутствие явных и потенциальных конфликтов интересов, связанных с публикацией настоящей статьи.
Читайте также:
